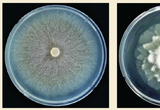

-
내 논에 사는 생물, 전문가와 함께 조사한다
- 2021-12-14 18:31
- 이은원 기자
-
전남도, 전국 친환경농업 기반사업 선도
- 2021-12-14 18:29
- 조윤아 기자
-

돌발해충 매미나방 생물학적 방제 성페로몬 개발
- 2021-12-03 10:12
- 차재선 기자
-

내년도 유기농업자재지원사업지침 ‘독소조항’ 수정 요청
- 2021-11-30 21:00
- 이은원 기자
-

더 늦기 전에 2050 탄소중립…범정부 탄소중립 주간 운영
- 2021-11-30 20:57
- 조윤아 기자
-

연작장해 해결…기능성 토양미생물제제가 뜬다
- 2021-11-11 20:39
- 차재선 기자
-

전천후 ‘식물추출 천연물질’ 농가 곁에 서다!
- 2021-11-11 19:55
- 차재선 기자
-

“와~! 진짜 ‘대박’…마늘은 그대로, 풀만 노랗게 죽어”
- 2021-11-11 19:52
- 차재선 기자
-

하우스 잿빛곰팡이 방제에 유기농업자재 ‘노재틴’
- 2021-11-11 18:39
- 이은원 기자
-

제초제 펜디메탈린 분해 곰팡이 2종 발굴
- 2021-11-11 18:36
- 한민혁 기자
-

하우스 잿빛곰팡이 방제에 유기농업자재 ‘노재틴’
- 2021-11-03 11:38
- 이은원 기자
-

내년 유기농업자재 비용지원 일반농가까지 확대
- 2021-11-02 15:20
- 이은원 기자
-

최고·최량의 기업 ‘융전’의 서막을 열다
- 2021-10-27 20:07
- 이은원 기자
-

학교에서도 코리아그린푸드데이 시작해요
- 2021-10-27 19:17
- 조윤아 기자
-

감귤 ‘화살깍지벌레’, 천적으로 막는 길 열렸다
- 2021-10-25 17:12
- 이은원 기자
-
친환경농업 가치확산 우수학교를 찾습니다
- 2021-10-19 11:25
- 한민혁 기자
-

스마트오션, 사과농가 사로잡은 신선도유지제
- 2021-10-12 15:11
- 이은원 기자
-

제5차 친환경농업 육성 5개년 계획 확정
- 2021-10-12 15:02
- 이은원 기자
-

제4차 친환경농업육성계획(2016~2020년) 성과 미진
- 2021-10-12 14:57
- 이은원 기자
-

한친농 제7대 회장에 정명출 ㈜상록 대표 취임
- 2021-09-11 19:58
- 이은원 기자
-

안인 한국친환경농식품자재수출조합 이사장 취임
- 2021-09-11 19:51
- 이은원 기자
-

농어업인 친환경자재 비용지원 법률 근거 마련
- 2021-09-01 12:56
- 이은원 기자
-

아열대‧특용작물서 ‘화분매개곤충’ 이용률 큰폭 늘어
- 2021-08-31 11:59
- 이은원 기자
-

(주)누보, 4종&기능성 자재 판매점 모집
- 2021-08-27 11:01
- 관리자 기자
- 1 중국 ‘농약 원제 환급세 폐지’…가격 흔드는 9% 변수
- 2 2025년 기본형 공익직불금 지급합니다
- 3 [인사] 농협중앙회 및 농협경제지주, 상무·지역본부장(2026년 1.1일자)
- 4 농협미래전략연구소, 2026년 주목해야 할 농업·농촌 10대 이슈 선정
- 5 농협케미컬 2026년 신제품 5종 출시 예정
- 6 농협중앙회, 농축협 조합장 불법선거 강력대응 할 것
- 7 “줄 서서 먹는 자두, 과학으로 키워요”
- 8 천지바이오, 농약·비료 효과UP 하는 ‘pH밸런스’ 출시
- 9 [새해 새 정책] 농어촌 기본소득 시범사업 도입
- 10 작물보호협회 신임 회장에 ‘한동우 SG한국삼공 대표’ 추대
- 테마기획농약 제조회사·유통업계 ‘초기방제·회전율’에 승부
- 정책코피아 신임 소장 5명 선발…개도국 농업기술 전파 나선다
- 농기계‘보광기술’로 딸기 개화·수확 앞당겨 생산량 23% 늘린다
- 농약농약 제조회사·유통업계 ‘초기방제·회전율’에 승부
- 친환경저탄소농업 ‘뜨거운 호응’…상반기 인증 650건 신청
- 비료‘비료 줄이고 환경 지키고~’…‘생분해 코팅’ 완효성 비료
- 종자NH농우 ‘피엠알303’, 재배 쉬운 흰가루 내병계 수박
- 농협농협개혁위, “돈 안 쓰는 선거, 공정·전문 인사” 혁신안 논의
- 글로벌 뉴스FMC, 세계 최초 ‘이중 작용 기작’ 제초제 분류 획득
- 오피니언농약 유통의 ‘경고등’ …균형이 필요하다
- 테마기획2025년 농약시장 2.7% 성장…회사별 실속은 엇갈렸다
- 정책2025년 기본형 공익직불금 지급합니다
- 농기계겨울철 농기계 ‘점검·정비’ 철저히 해 보관해야
- 농약중국 ‘농약 원제 환급세 폐지’…가격 흔드는 9% 변수
- 친환경송옥주 의원, ‘친환경농어업 두배 확대’ 개정안 발의
- 비료천지바이오, 농약·비료 효과UP 하는 ‘pH밸런스’ 출시
- 종자국산 41% 돌파 ‘케이(K)-고구마 시대’ 온다
- 농협농협미래전략연구소, 2026년 주목해야 할 농업·농촌 10대 이슈 선정
- 글로벌 뉴스중국 ‘농약 원제 환급세 폐지’…가격 흔드는 9% 변수
- 오피니언농기자재 산업이 서 있는 자리를 되돌아 봅니다